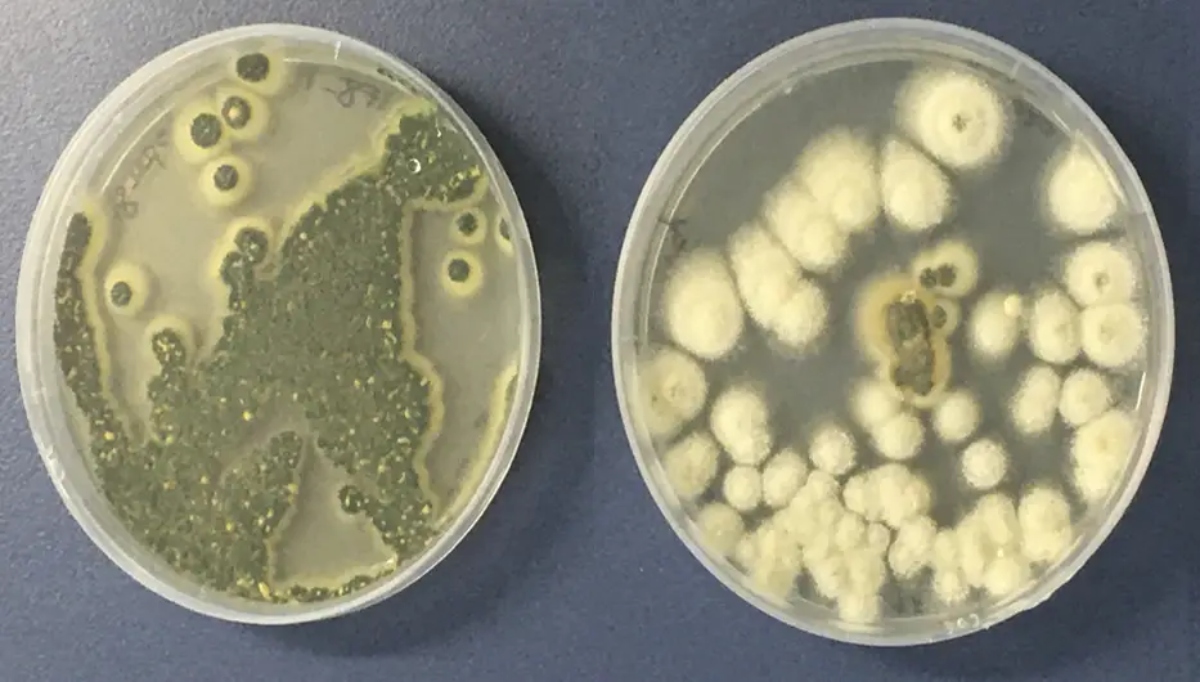
Aspergillus, el hongo letal

Mientras el planeta continúa calentándose, una amenaza silenciosa pero potencialmente mortal está expandiendo su alcance.
El Aspergillus fumigatus, un hongo capaz de causar infecciones graves que pueden «devorar» a sus víctimas desde el interior, podría extender significativamente su territorio debido al cambio climático, según revela una nueva investigación científica.
Este hongo, responsable de millones de infecciones y hasta 2,5 millones de muertes anuales en todo el mundo, podría ampliar su rango de distribución en un alarmante 77% para el año 2100. Las proyecciones indican que alcanzará regiones más septentrionales de Europa, Asia y las Américas, exponiendo potencialmente a 9 millones más de personas solo en Europa.
El Aspergillus fumigatus es un moho común presente en el suelo, el compost y ambientes interiores. Lo que lo hace particularmente peligroso es su capacidad para prosperar a 37°C, precisamente la temperatura del cuerpo humano. Esta característica le permite colonizar eficazmente los pulmones humanos cuando sus esporas son inhaladas.
«Estamos hablando de cientos de miles de vidas y cambios continentales en la distribución de especies», advierte el Dr. Norman van Rhijn, investigador de la Universidad de Manchester y autor principal del estudio. «En 50 años, dónde crecen las cosas y de qué te infectas será completamente diferente».
El hongo causa la aspergilosis, una enfermedad pulmonar que puede extenderse a otros órganos y resulta especialmente peligrosa para personas con sistemas inmunitarios debilitados. Según los Centros para el Control y la Prevención de Enfermedades de EE.UU., es «la principal causa de infecciones por moho invasivas en personas» y los infectados tienen un 33% más de probabilidades de morir.
Un problema de salud global subestimado
Los hongos patógenos representan una amenaza seria para la salud humana que a menudo pasa desapercibida. La Organización Mundial de la Salud ha identificado al Aspergillus fumigatus como una de las cuatro principales amenazas fúngicas a nivel mundial.
El problema se agrava por varios factores:
- Las infecciones fúngicas a menudo no se diagnostican correctamente debido a la superposición de síntomas con otras enfermedades.
- Existe una falta generalizada de conciencia sobre las enfermedades fúngicas.
- Las opciones de tratamiento son limitadas.
- Está aumentando la resistencia a los medicamentos antifúngicos.
- Hay poca inversión en el desarrollo de nuevos tratamientos.
«Los patógenos fúngicos representan una amenaza seria para la salud humana al causar infecciones y alterar los sistemas alimentarios», explica Viv Goosens, gerente de investigación en Wellcome Trust, que financió la investigación. «El cambio climático empeorará estos riesgos. Para abordar estos desafíos, debemos llenar importantes lagunas de investigación».
No solo Aspergillus fumigatus: otras especies también se expanden
El estudio también analizó otras especies de Aspergillus. El Aspergillus flavus, que infecta cultivos y produce aflatoxinas (compuestos tóxicos que pueden causar cáncer de hígado), podría expandirse a un 16% más de territorio, incluyendo el norte de China, Rusia, Escandinavia y Alaska, mientras retrocede en áreas de África y Brasil.
Utilizando modelado climático y pronósticos, los investigadores han mapeado cómo podrían cambiar las distribuciones globales de tres patógenos fúngicos (Aspergillus flavus, Aspergillus fumigatus y Aspergillus niger) como resultado del cambio climático hasta el año 2100.
La adaptabilidad de los hongos: una ventaja evolutiva preocupante
Los hongos son organismos increíblemente adaptables, con genomas grandes y maleables que les permiten colonizar nuevas geografías y sobrevivir a medida que cambia su entorno. Esta capacidad de adaptación es precisamente lo que los hace tan peligrosos en un mundo que se calienta.
«Los cambios en factores ambientales, como la humedad y los eventos climáticos extremos, cambiarán los hábitats e impulsarán la adaptación y propagación de hongos», explica el Dr. van Rhijn. «Ya hemos visto la aparición del hongo Candida auris debido al aumento de las temperaturas, pero, hasta ahora, teníamos poca información sobre cómo otros hongos podrían responder a este cambio en el entorno».
El espectro de enfermedades causadas por Aspergillus
En la especie humana, el Aspergillus puede producir un amplio espectro de sintomatologías correlacionadas con el tipo e intensidad de la respuesta inmune del paciente. Estas se agrupan en cuatro síndromes principales:
- Aspergilosis broncopulmonar alérgica
- Aspergiloma
- Aspergilosis pulmonar necrotizante crónica
- Aspergilosis invasiva
Además, existen otras formas de infección tras diseminación hematógena o contaminación periquirúrgica.
La aspergilosis invasiva es particularmente grave, con una tasa de mortalidad elevada entre el 91% y el 95%. Un factor relevante son las dificultades diagnósticas, derivadas de la inespecificidad de la presentación clínica y de la ausencia de pruebas complementarias no invasivas que puedan considerarse definitivas.
Curiosidades científicas sobre los hongos patógenos
El mecanismo molecular del daño
El mecanismo por el cual el Aspergillus fumigatus causa daño aún no ha sido totalmente elucidado, aunque estudios in vitro han demostrado que al emplear filtrados de cultivo de este hongo se producen daños en el epitelio respiratorio humano. Se considera que este daño está asociado a la existencia de un compuesto de bajo peso molecular identificado como Gliotoxina.
Crecimiento «asombrosamente rápido»
Según Elaine Bignell, codirectora del Centro MRC para Micología Médica de la Universidad de Exeter, el Aspergillus fumigatus crece «asombrosamente rápido» en entornos cálidos, lo que explica por qué el aumento de las temperaturas globales favorece su proliferación.
No todos los hongos son perjudiciales
A pesar de las amenazas que representan algunas especies, es importante recordar que los hongos también nos benefician directamente: hay hongos que usamos para alimentarnos, para producir medicamentos como la penicilina, o incluso para hacer pan y cerveza. Su aporte en la medicina, la gastronomía y la biotecnología es increíblemente valioso.
La referencia a «The Last of Us»
El Dr. Norman van Rhijn, autor principal del estudio, hizo referencia a la popular serie «The Last of Us», que trata sobre una infección fúngica que causa un apocalipsis, diciendo que «la realidad ya es lo suficientemente aterradora». Aunque la serie es ficción, los científicos señalan que las amenazas fúngicas reales merecen mucha más atención.
Un caso real en Chile
En mayo de 2025, el hongo Aspergillus obligó a cerrar cinco pabellones de un hospital público en Chile. Este incidente demuestra cómo estos patógenos pueden afectar incluso a instalaciones sanitarias modernas. La aspergilosis pulmonar que causa este hongo afecta principalmente a personas inmunocomprometidas y puede ser mortal si no se recibe tratamiento oportuno.
Resistencia a los medicamentos: una crisis silenciosa
La mayoría de los patógenos fúngicos identificados como prioritarios por la Organización Mundial de la Salud, y que están ligados a cerca de 3,8 millones de muertes al año en todo el mundo, ya son resistentes a los antibióticos o están adquiriendo esas resistencias.
Para alertar de la gravedad de la amenaza y de la importancia de acelerar el estudio, un equipo internacional de investigadores de once países publicó recientemente una carta en la revista científica The Lancet en la que piden más atención y más recursos para combatir las resistencias a los tratamientos en patologías causadas por hongos.
Los científicos advierten que, si no se toman medidas, las enfermedades fúngicas podrían convertirse en una de las próximas grandes crisis de salud pública a medida que el planeta continúa calentándose. La combinación de expansión territorial, aumento de la exposición humana y resistencia a los medicamentos crea una tormenta perfecta que requiere atención urgente.
En un mundo que aún se recupera de la pandemia de COVID-19, estas advertencias sobre patógenos emergentes cobran especial relevancia. Las lecciones aprendidas sobre preparación, vigilancia y respuesta rápida deberían aplicarse ahora a la amenaza creciente de las enfermedades fúngicas antes de que se conviertan en la próxima crisis sanitaria global.